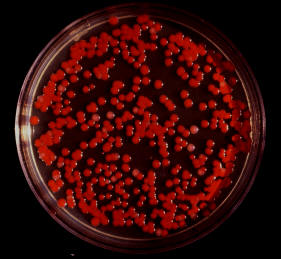

-
"Wenn ich seit Juli (als eine Absichtserklärung zwischen der Region und den Betreibern unterzeichnet wurde, um Brüssel zur ersten belgischen Stadt zu machen, in der die 5G bis 2020 stattfindet, Anm. L´Echo) nicht aufgehört habe, mich mit diesem Thema anhand einer ganzen Reihe grundlegender Gesundheitsrichtlinien zu beschäftigen, muss heute gesagt werden, dass es für mich undenkbar ist, die Einführung dieser Technologie zu erlauben, wenn ich die Einhaltung der Normen zum Schutz der Bürger nicht sicherstellen kann. 5G oder nicht. Die Brüsseler sind keine Labormäuse, deren Gesundheit ich mit Gewinn verkaufen kann. Daran kann es keinen Zweifel geben."
Keine Frage: Rezos Kritik an der CDU ist berechtigt und mir geht es
nicht darum, die CDU dagegen zu verteidigen. Aber warum muss er diese
Kritik mit einer Werbung für die von den üblichen Hintegrundkräften
inszenierte Bewegung „Fridays for Future“ verbinden, durch die Kinder
unbewusst die zukünftige Abschaffung ihrer Freiheit (Digitalisierung des
Alltags zwecks Überwachung durch 5G) mitfördern und auf die Akzeptanz
von überhöhten Energiesteuern vorbereitet werden?
Und warum muss Rezo in seinem video die Klimalüge von der
menschengemachten Erderwärmung bestätigen? Und ferner: Schon haufenweise
Youtuber haben die CDU kritisiert... warum wird da jetzt gerade Rezo
zufälligerweise dermaßen rausgepickt, dass er bereits jetzt in der
Öffentlichkeit der System-Medien steht?
Und warum wird das Ganze jetzt sogar dadurch gesteigert, dass Rezo von
CDU-Generalsekretär Paul Ziemak zu einem persönlichen Gepräch eingeladen
wird, damit die CDU Rezos Kritik beantworten kann? Siehe hier:
https://www.t-online.de/nachrichten/deutschland/parteien/id_85804540/rezos-die-zerstoerung-der-cdu-partei-arbeitet-mit-brief-auf-kritisches-video.html
Soll uns hier vorgegaukelt werden, eine normale Privat-Person könne
durch ein Home-Video die komplette Aufmerksamkeit der öffentlichen
Medien und des Bundestags erreichen? Nein, das kann man als normale
Privat-Person nicht, sondern nur wenn man gezielt vom System als
Mariontte für Schüler eingesetzt wird wie Greta Thunberg oder halt
besagter Rezo. Diese Einladung des CDU-Generalsekretärs an Rezo erinnert
mich an den Youtuber LeFloyd, der erst auch systemkritisch auf TTIP
losging, dann auf einmal die Ehre haben durfte, Angela Merkel persönlich
zu interviewen und seitdem immer positiver über die Bundesregierung
berichtete.
Lasst euch gewarnt sein: Auch ein Rezo wird mit sehr starker
Wahrscheinlichkeit dafür bezahlt, derlei Videos zu produzieren... da in
ihnen trotz aller berechtigter System-Kritik immer noch ein höherer
Gewinn für das System versteckt ist: Nämlich der Glaube an die
Klimalüge, welcher unentbehrlich ist um die Menschen widerstandslos in
den Überwachungs-Staat der NWO zu überführen. Von ARD und ZDF bezahlte
Youtuber, die besonders die Jüngeren mit etwas „Flow“ ansprechen sollen,
gibt es immer wieder: Mr. Wissen to Go, LeFloyd und Eva Schulz Würde
mich nicht wundern, wenn man den Rezo bald wie LeFloyd in der Sendung
von Markus Lanz sieht...